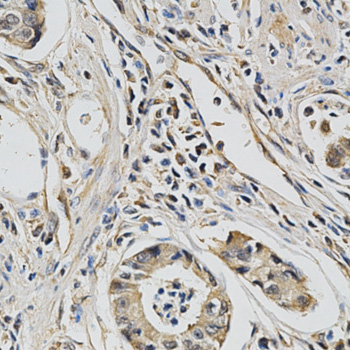
A2162: image 4

For quotations, please use our online quotation form, and you may also contact us by
sales@neoscientific.com
+1-888.733.6849
+1-617.299.7367 (Int’l)
+1-888.733.6849
+1-617.299.7367 (Int’l)
| Reactivity | Human Mouse Rat |
| Tested applications | WB IHC ICC IP |
| Recommended Dilution | WB 1:500 - 1:2000 IHC 1:50 - 1:100 ICC 1:50 - 1:200 IP 1:50 - 1:100 |
| Calculated MW | 29kDa |
| Observed MW | Refer to Figures |
| Immunogen | Recombinant protein of human EIF4E |
| Storage Buffer | Store at -20℃. Avoid freeze / thaw cycles. Buffer: PBS with 0.02% sodium azide, 50% glycerol, pH7.3. |
| Synonym | CBP; EIF4E1; EIF4EL1; EIF4F; MGC111573; |

Western blot analysis of extracts of various cell lines, using EIF4E antibody. .

Immunohistochemistry of paraffin-embedded human kidney using EIF4E antibody at dilution of 1:200 (40x lens).

Immunohistochemistry of paraffin-embedded human esophageal cancer using EIF4E antibody at dilution of 1:200 (40x lens).
Immunohistochemistry of paraffin-embedded human stomach cancer using EIF4E antibody at dilution of 1:200 (40x lens).

Immunohistochemistry of paraffin-embedded human lung cancer using EIF4E antibody at dilution of 1:100 (40x lens).

Immunohistochemistry of paraffin-embedded human stomach using EIF4E antibody at dilution of 1:100 (40x lens).
Eukaryotic initiation factor 4E (eIF4E) binds to the mRNA cap structure to mediate the initiation of translation (1,2). eIF4E interacts with eIF4G, a scaffold protein that promotes assembly of eIF4E and eIF4A into the eIF4F complex (2). eIF4B is thought to assist the eIF4F complex in translation initiation. Upon activation by mitogenic and/or stress stimuli mediated by Erk and p38 MAPK, Mnk1 phosphorylates eIF4E at Ser209 in vivo (3,4). Two Erk and p38 MAPK phosphorylation sites in mouse Mnk1 (Thr197 and Thr202) are essential for Mnk1 kinase activity (3). The carboxy-terminal region of eIF4G also contains serum-stimulated phosphorylation sites, including Ser1108, Ser1148, and Ser1192 (5). Phosphorylation at these sites is blocked by the PI3 kinase inhibitor LY294002 and by the FRAP/mTOR inhibitor rapamycin.
N/A